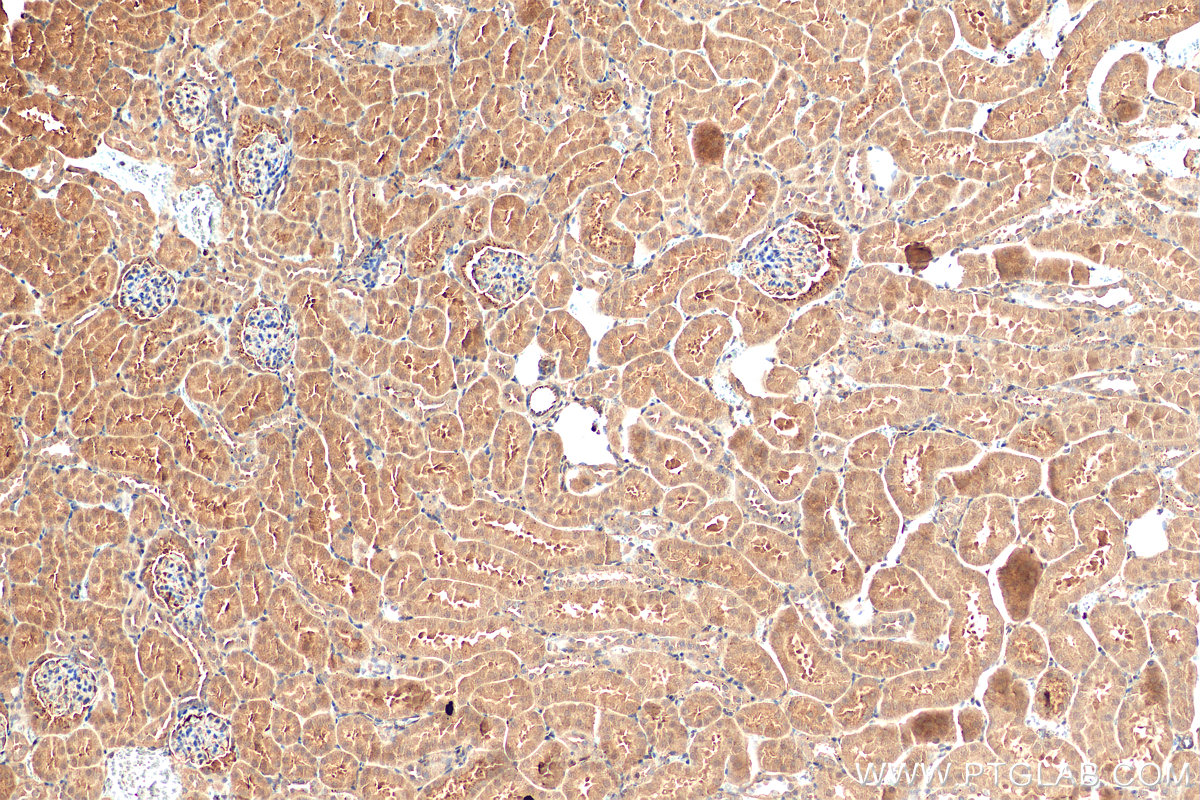

验证数据展示
经过测试的应用
| Positive WB detected in | mouse liver tissue |
| Positive IHC detected in | human kidney tissue, rat kidney tissue, mouse kidney tissue Note: suggested antigen retrieval with TE buffer pH 9.0; (*) Alternatively, antigen retrieval may be performed with citrate buffer pH 6.0 |
推荐稀释比
| 应用 | 推荐稀释比 |
|---|---|
| Western Blot (WB) | WB : 1:500-1:1000 |
| Immunohistochemistry (IHC) | IHC : 1:50-1:500 |
| It is recommended that this reagent should be titrated in each testing system to obtain optimal results. | |
| Sample-dependent, Check data in validation data gallery. | |
发表文章中的应用
| KD/KO | See 1 publications below |
| IF | See 1 publications below |
产品信息
51109-1-AP targets Angptl4 in WB, IHC, IF, ELISA applications and shows reactivity with human, mouse, rat samples.
| 经测试应用 | WB, IHC, ELISA Application Description |
| 文献引用应用 | IF |
| 经测试反应性 | human, mouse, rat |
| 文献引用反应性 | human, mouse |
| 免疫原 |
CatNo: Ag0613 Product name: Recombinant rat Angptl4 protein Source: e coli.-derived, PET28a Tag: 6*His Domain: 1-405 aa of BC078944 Sequence: MRCAPTAGAALVLCAATAGLLSAQGRPAQPEPPRFASWDEMNLLAHGLLQLGHGLREHVERTRGQLGALERRMAACGNACQGPKGTDPKDRVPEGQAPETLQSLQTQLKAQNSKIQQLFQKVAQQQRYLSKQNLRIQNLQSQIDLLTPTHLDNGVDKTSRGKRLPKMAQLIGLTPNATRLHRPPRDCQELFQEGERHSGLFQIQPLGSPPFLVNCEMTSDGGWTVIQRRLNGSVDFNQSWEAYKDGFGDPQGEFWLGLEKMHSITGDRGSQLAVQLQDWDGNAKLLQFPIHLGGEDTAYSLQLTEPTANELGATNVSPNGLSLPFSTWDQDHDLRGDLNCAKSLSGGWWFGTCSHSNLNGQYFHSIPRQRQQRKKGIFWKTWKGRYYPLQATTLLIQPMEATAAS 种属同源性预测 |
| 宿主/亚型 | Rabbit / IgG |
| 抗体类别 | Polyclonal |
| 产品类型 | Antibody |
| 全称 | angiopoietin-like 4 |
| 别名 | Hepatic fibrinogen/angiopoietin-related protein, ANGPTL4 N-terminal chain, ANGPTL4 C-terminal chain, Angiopoietin-related protein 4, Angiopoietin-like protein 4 |
| 计算分子量 | 405 aa, 45 kDa |
| GenBank蛋白编号 | BC078944 |
| 基因名称 | Angptl4 |
| Gene ID (NCBI) | 362850 |
| 偶联类型 | Unconjugated |
| 形式 | Liquid |
| 纯化方式 | Antigen affinity purification |
| UNIPROT ID | Q6TMA8 |
| 储存缓冲液 | PBS with 0.02% sodium azide and 50% glycerol, pH 7.3. |
| 储存条件 | Store at -20°C. Stable for one year after shipment. Aliquoting is unnecessary for -20oC storage. |
背景介绍
Angiopoietin-like protein 4 (ANGPTL4), a member of the angiopoietin-like protein subfamily, is a secretory protein that functions as an important modulator of glucose and lipid metabolism. ANGPTL4 inhibits lipoprotein lipase (LPL)-dependent lipolysis thereby limiting the uptake of free fatty acids. Overexpression of ANGPTL4 results in hypertriglyceridemia, while ANGPTL4 deficiency suppresses foam formation in macrophages and protects against atherosclerosis. ANGPTL4 may play a role in several cancers and it also has been shown to prevent the metastatic process by inhibiting vascular activity as well as tumor cell motility and invasiveness. Decreased expression of this protein has been associated with type 2 diabetes. ANGPTL4 has three functional domains: the signal peptide, the coiled-coil (N-terminal chain, CCD), and the fibrinogen-like (C-terminal chain, FLD) domains. ANGPTL4 is a glycosylated secreted protein (fANGPTL4, 45-65 kDa). fANGPTL is then rapidly post-translationally cleaved into an N-terminal coiled-coil domain (nANGPTL4, ~ 15 kDa) and a C-terminal fibrinogen-like domain (cANGPTL4, ~ 35 kDa)(PMID: 37300585 ).
实验方案
| Product Specific Protocols | |
|---|---|
| IHC protocol for Angptl4 antibody 51109-1-AP | Download protocol |
| WB protocol for Angptl4 antibody 51109-1-AP | Download protocol |
| Standard Protocols | |
|---|---|
| Click here to view our Standard Protocols |